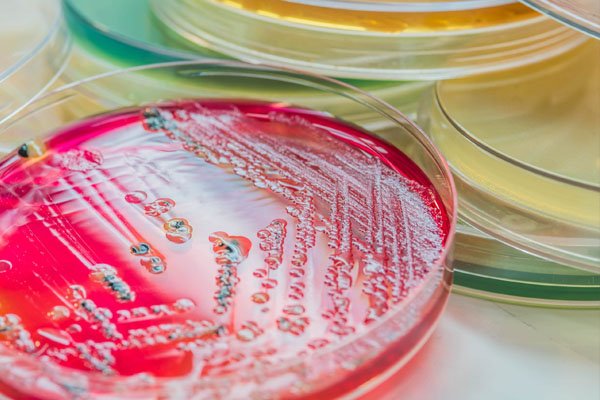

About Us
Contact Info
-
-
Phone
+91 9816632049 -
It is a long established fact that a reader will be distracted by the readable content of the when looking layout.
It is a long established fact that a reader will be distracted by the readable content of the when looking layout.
It is a long established fact that a reader will be distracted by the readable content of the when looking layout.


Years Of Experience
Welcome to the world of construction innovation, where Mayfair Biotech Pvt Ltd stands tall as a leading manufacturer of top-notch water born polymer emulsion and specialized chemicals which are used in diverse industrial sectors that include construction materials, paint, waterproofing, textiles, paper, flexible packaging, furniture and furnishing, woven and tufted carpets as well as non-woven fabrics and carpets, garment printing and all types of textile printing, electronics, agriculture seed coating, aerospace, and biotechnology. in India.

Paint Binders (also known as resins) are one of the most critical components in any paint formulation.
Learn More
Textile Printing Binders are essential chemicals used in pigment printing processes to fix pigments onto fabric surfaces.
Learn More
Textile Coating Binders are specialized polymer emulsions used to form a continuous film over the fabric surface
Learn More
Textile Process Emulsions are specialty chemical emulsions used in various stages of textile manufacturing
Learn More
Lamination and Packaging Adhesives are specialty adhesives used to bond multiple layers of materials
Learn More
Pressure Sensitive Adhesives (PSAs) are a special class of adhesives that stick to surfaces with just light pressure.
Learn More
1. Simple & Clear:
We offer the best textile printing binder solutions tailored to your fabric and process needs.
2. More Professional:
Delivering high-performance textile printing binders designed for superior pigment fixation, softness,
and durability.
3. With Service Emphasis:
We specialize in providing reliable textile printing binder services with a focus on quality,
consistency, and customer satisfaction.